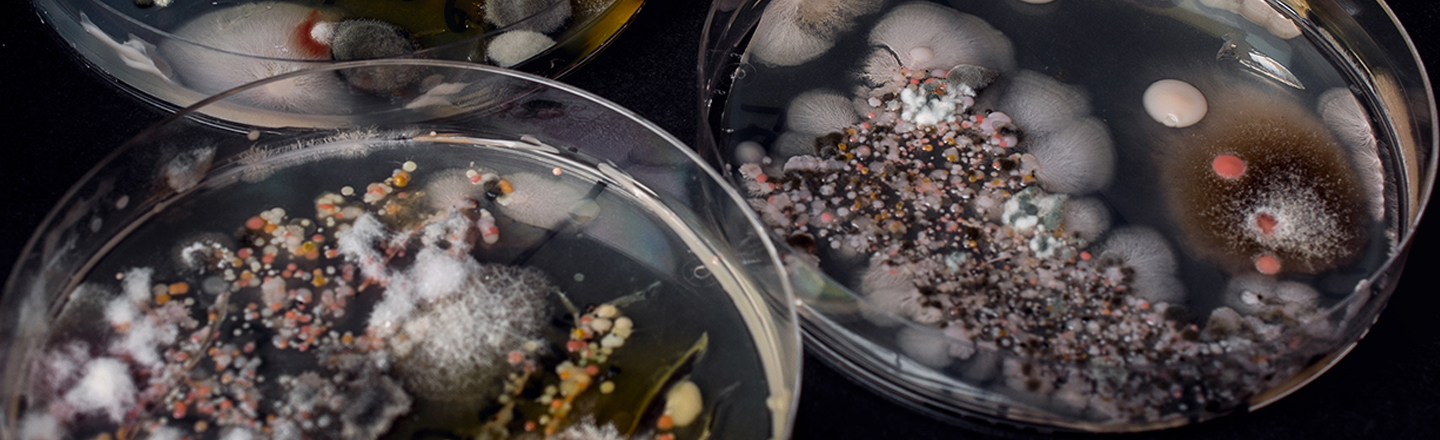
Fungi Samples in Petri Dishes

What You'll Study
The Department of Biology offers Bachelor degrees in Biology (B.S. and B.A.) with optional Biology Research concentration, as well a minor in Biology. By employing a curriculum that emphasizes scientific inquiry and problem-solving, we aim to develop in you the fundamental skills and knowledge for entering a wide range of careers, including those in medicine, environmental science, research and teaching.
Graduates of our program pursue a variety of interests and passions upon graduation, including medical school, PhD programs in specialties such as molecular biology, conservation ecology, and neurobiology, and a number of graduates are selected for prestigious volunteer posts with the Peace Corps, Teach for America, and the Jesuit Volunteer Corps.
Gonzaga Launches Careers
"Study abroad in Costa Rica, summer research, and labs outdoors helped me understand that working outdoors is a possibility and was a career path I definitely wanted to pursue."
Biology Undergraduate Education and Research
We have a long history of providing high-quality science education in both the classroom and the research lab and have been recognized by the Howard Hughes Medical Institute, which has awarded the Department competitive grants for its innovations in undergraduate education and research. Our department is among a small group of universities across the country that involves all introductory biology students in authentic discovery-based research.